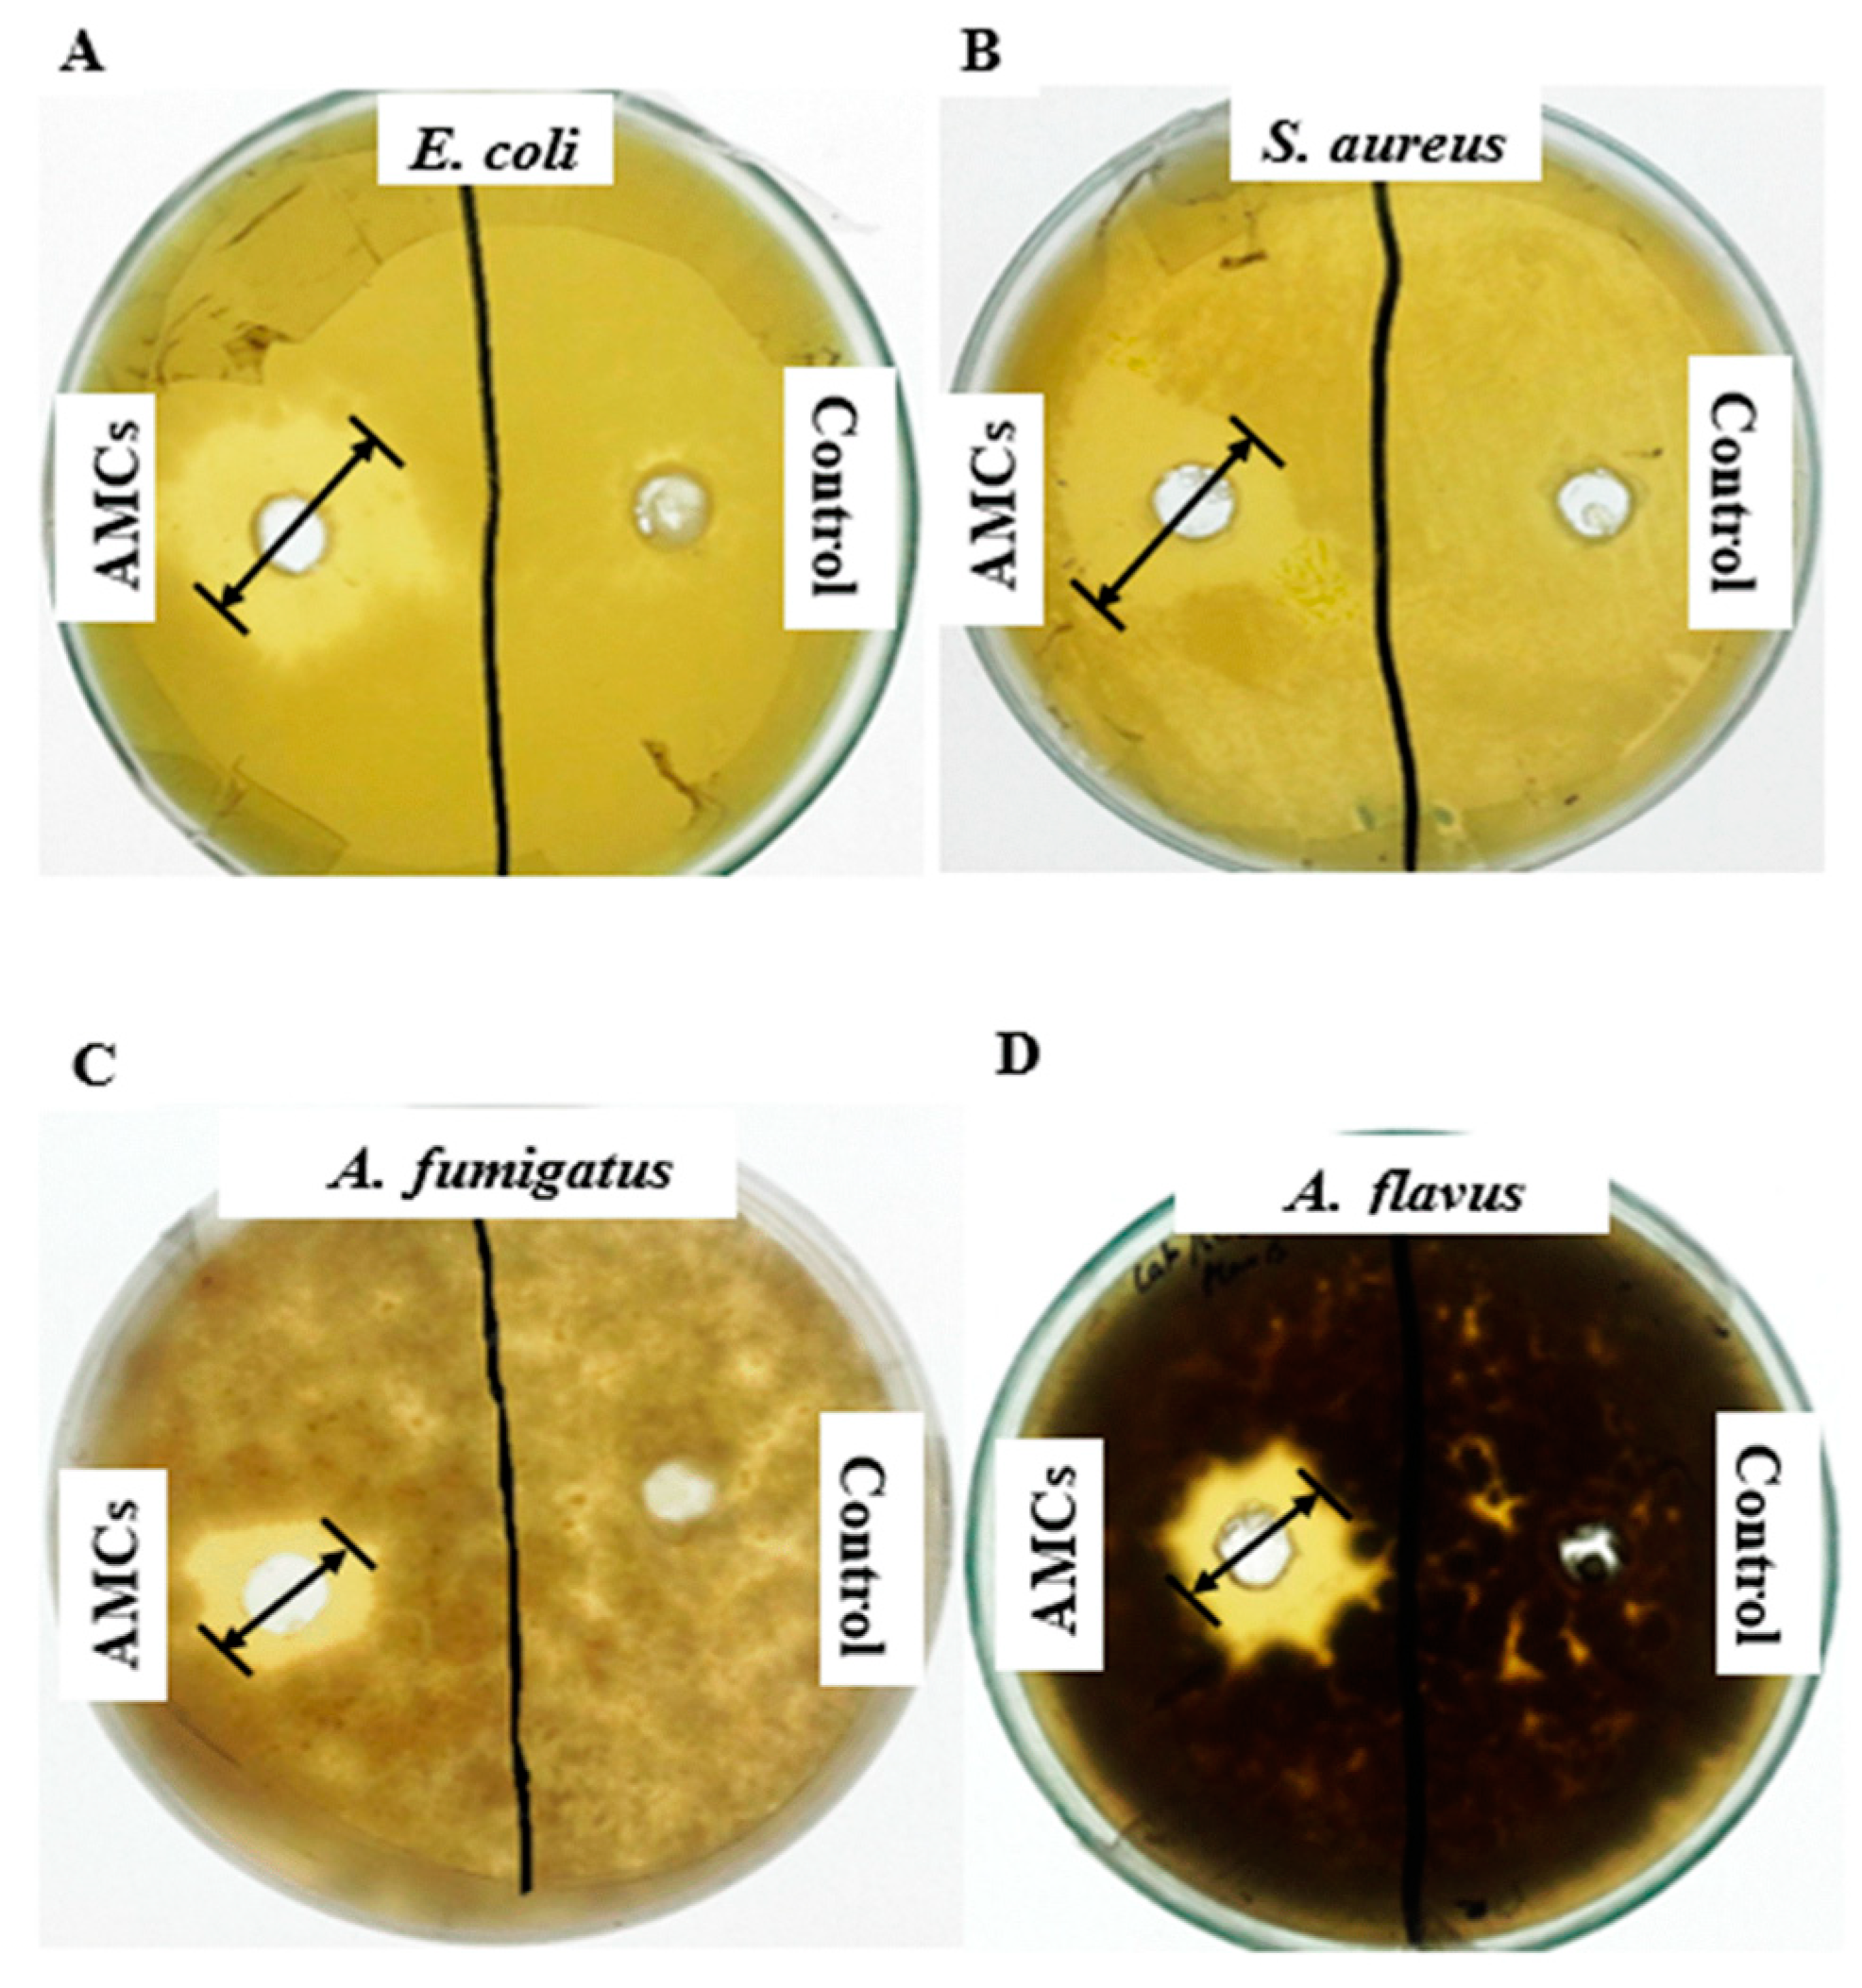
Molecules 25 04685 g001 Molecules 25 04685 g001
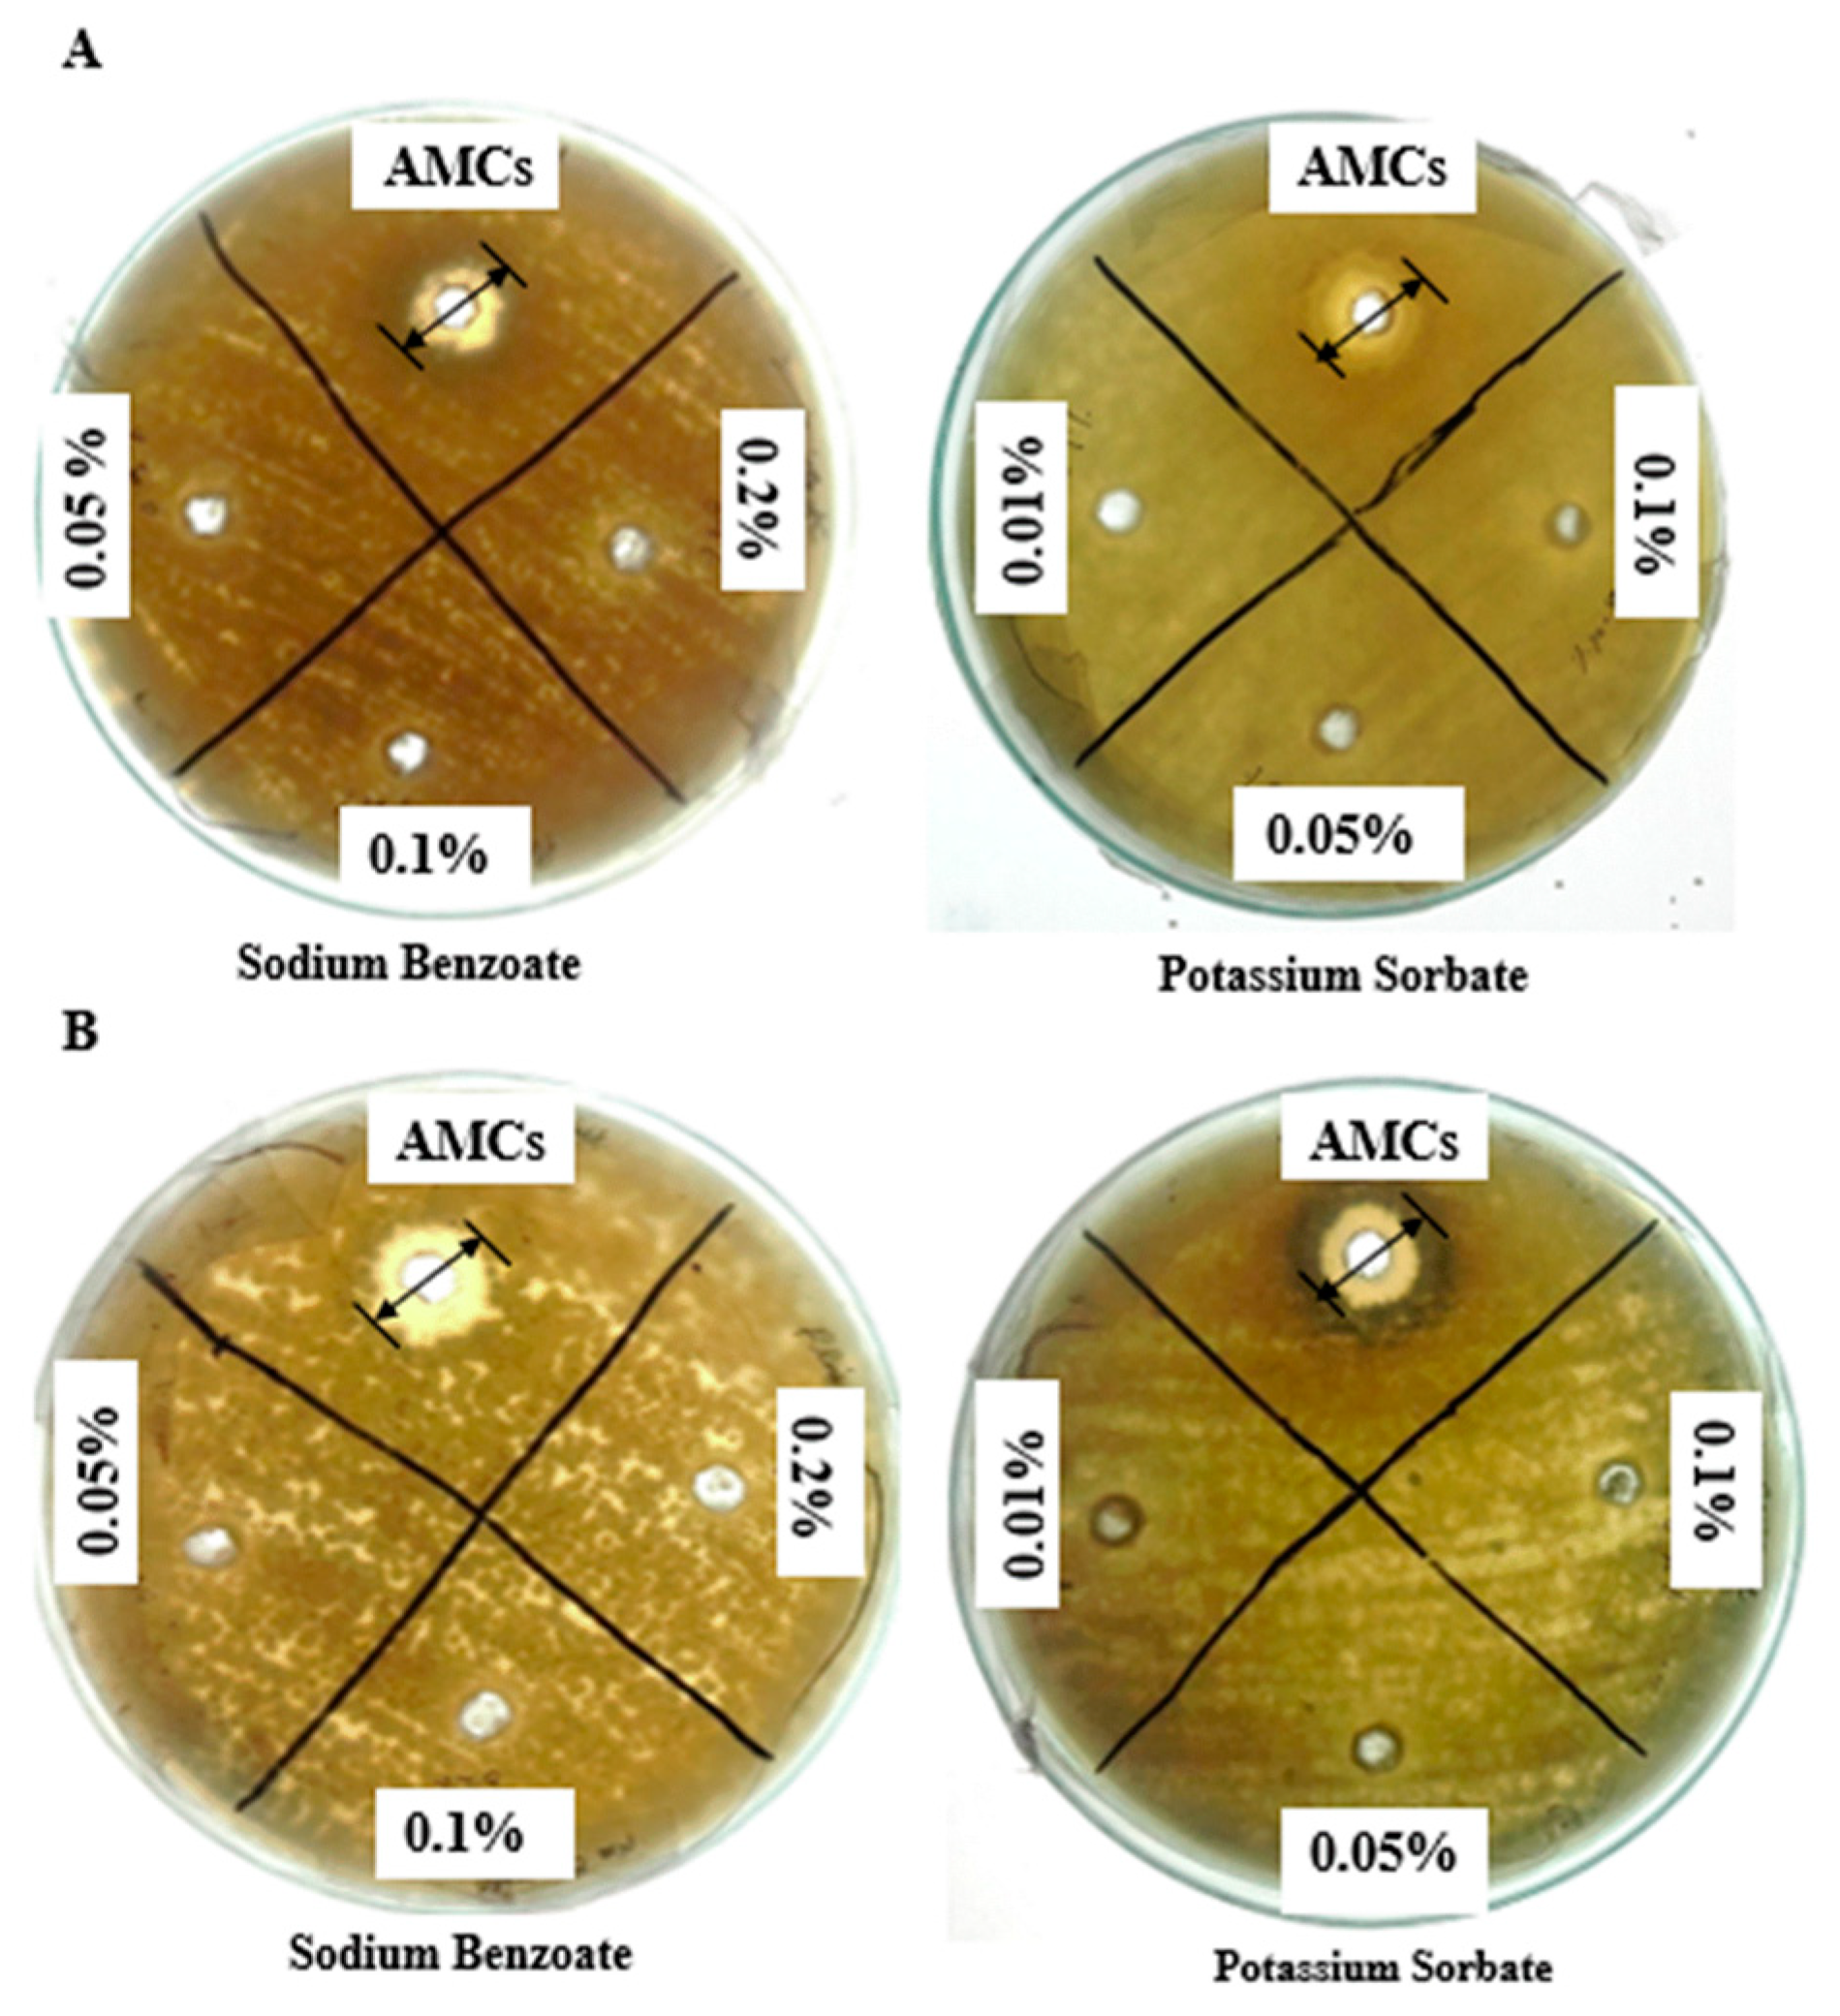
Molecules 25 04685 g002 Molecules 25 04685 g002
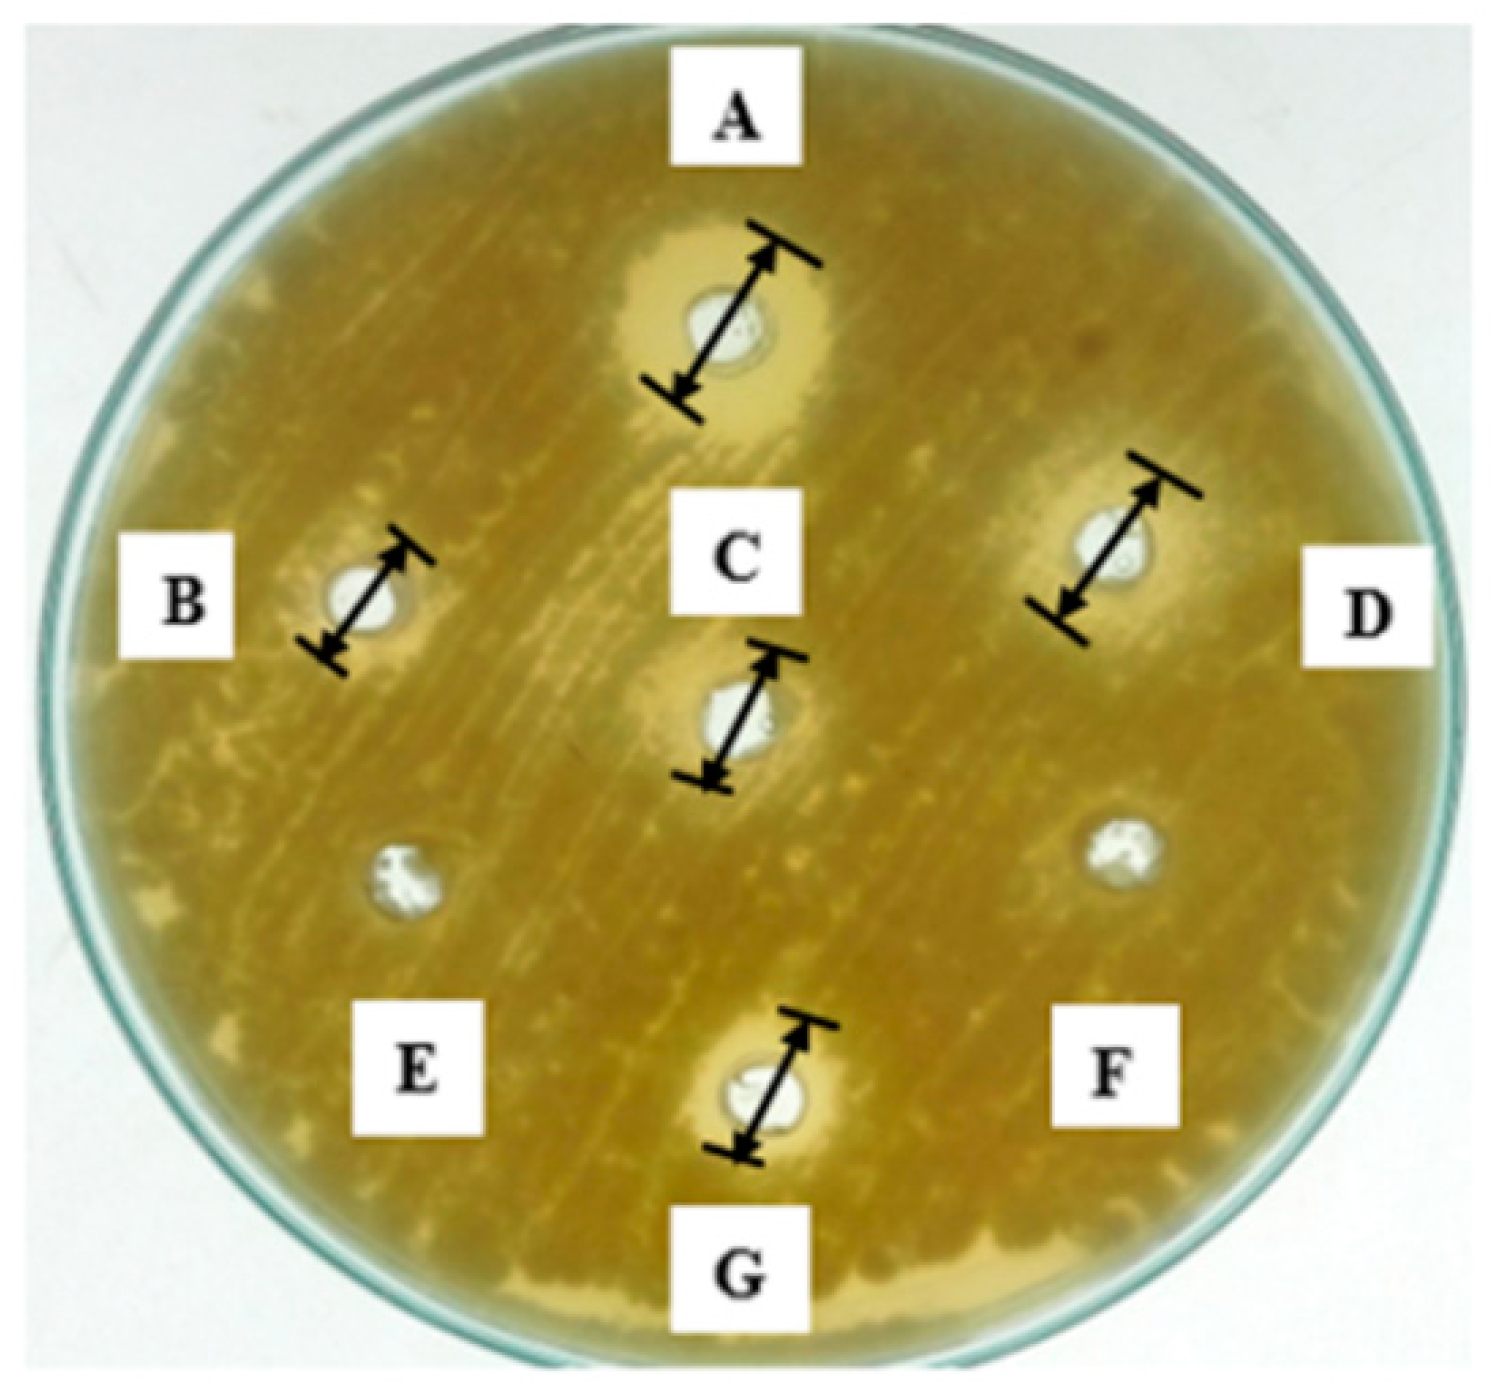
Molecules 25 04685 g005 Molecules 25 04685 g005

Abstract
Lactic acid bacteria (LAB) can synthesize antimicrobial compounds (AMCs) with nutritional and bioprotective properties in crops and food products. In the current study, AMCs of Lactobacillus coryniformis BCH-4 were evaluated to control fungal spoilage in maize grains. On maize grains treated with 75%–100% (v/v) concentrated AMCs, no fungal growth was observed even after 72 h of Aspergillus flavus inoculation. Proximate analysis of treatments A1 (raw grains), A2 (A. flavus inoculated grains) and A3 (A. flavus + AMCs inoculated grains) revealed that moisture was significantly (p ≤ 0.05) high in A2 than A3 and A1. Meanwhile, protein, fat, fiber and ash contents were significantly decreased in A2 compared to A1 and A3. Moreover, β-carotene contents were not statistically different between A1 and A3, while in A2 it was significantly decreased. HPLC analysis revealed the presence of 2-oxopropanoic acid, 2-hydroxypropane-1,2,3-tricarboxylic acid, 2-hydroxybutanedioic acid, 2-hydroxypropanoic acid, propanedioic acid and butanedioic acid, which also showed antifungal activity against Aspergillus flavus. FTIR spectroscopy revealed the presence of hydroxyl, carbonyl and ester-groups along with organic and fatty acids, thereby indicating their participation in inhibitory action. Furthermore, the AMCs were found to be a good alternative to chemical preservatives, thereby not only preserving the nutritive qualities but increasing the shelf life as well.
1. Introduction
Deterrence of food from pathogenic microorganisms has always been a major task. The harmful products of these microorganisms endanger human as well as animal health [1]. Moreover, the high yield potential of plant species and crop cultivars become increasingly prone to diseases because of many pathogenic microorganisms that are major causative agents of spoilage, including bacteria, viruses, yeast and fungi [2]. Among them, pathogenic fungi (e.g., Blumeria graminis, Aspergillus flavus, Botrytis cinerea) are a major challenge to crops as they produce various toxic products, e.g., aflatoxins, linoleic acid, botcinic acid and their derivatives, which ultimately damage plants and spoil their products [3,4,5]. Fungi are etiological agents in many crop diseases and account for substantial losses at both pre- and post-harvest stages of crop production [6]. The financial losses due to post-harvest spoilage of cereal crops often appear in the form of low yield [2].
The production of cereal grains varies yearly; these grains should be stored from the year of over-production to the year of under-production. These stored grains can lose their quality because post-harvested cereal grains are influenced by various biotic and abiotic factors [7]. Among them, moisture is the most important factor regarding seed viability during storage. The moisture content above 13% in starchy cereal grains, namely wheat, rice and maize, leads to the invasion of storage fungi (predominant fungal genera include Aspergillus, Alternaria, Cladosporium, Fusarium, Mucor, Rhizopus and Penicillium) as the storage time and temperature increases [8,9].
Maize (Zea mays L.) ranks the 3rd most important cereal grain worldwide, after wheat and rice. It is a multipurpose crop being used as a staple food, for feed and biofuel production. The demand for maize in the developing countries is expected to double by 2050 [10]. The fungal genera that commonly infect maize are Fusarium, Penicillium, Rhizopus, Aspergillus and Tilletia. Fungal infection results in discoloration, lower nutritional values, and reduced quality and yield. Moreover, these pathogens also cause maize rot, kernel discoloration, loss of viability, mycotoxin contamination and subsequent seedling blights [11,12]. Chemical preservatives such as benzoates, nitrates and sorbates have been extensively used for the protection of post-harvested cereal grains; however, the use of such preservatives ultimately affects the nutritional qualities of grains [13,14]. In order to look for alternatives, beneficial microorganisms and their end products such as lactic acid bacteria, e.g., Lactobacillus plantarum [1], L. acidophilus, L. delbrueckii [15] and Lactococcus lactis [16] have been identified by researchers to overcome a high susceptibility to spoilage and to get good quality, chemical preservative-free food as demanded by the consumers [17].
Lactic acid bacteria (LAB) have been widely used for bioprotection purposes to enhance the shelf life of food [18]. LAB being used as biopreservative organisms are of prime significance; they have been employed for years as a starter culture in food industries. They increase the shelf life of food because of their inhibitory actions on food borne pathogenic microorganisms [19]. They are present normally in gut microbiota and in several dairy products, such as fermented milk and cheese, and play an important role in human health following oral administration [20]. These bacteria produce a variety of bioactive compounds including organic acids, phenyl lactic acid, bacteriocins, cyclic dipeptides, reuterin and hydrogen peroxide [21,22,23].
Lactobacillus coryniformis is a facultative anaerobic species of lactic acid-producing bacteria. This strain produces broad spectrum antimicrobial compounds (AMCs) such as lactic acid, acetic acid, hydrogen peroxide, bacteriocins and reuterin (3-hydroxypropionaldehyde, 3-HPA) [24]. It has shown inhibitory activity against molds Aspergillus fumigatus, A. nidulans, Penicillium roqueforti, Mucor hiemalis, Talaromyces flavus, Fusarium poae, F. graminearum, F. culmorum, and F. sporotrichoides [25]. In the present study, the focus was on the extraction of bioactive compounds from L. coryniformis BCH-4 to elucidate in vitro antimicrobial and antioxidant activities. The potential of AMCs for bioprotection of maize grains to overcome post-harvest loss has also been evaluated. Furthermore, high-performance liquid chromatography (HPLC) analysis was carried out to identify and determine the concentration of organic acids in AMC extracts. The functional groups were determined by Fourier Transform Infrared (FTIR) Spectroscopy. This is the first report of its kind, as no work has been reported earlier for the bioprotection of post-harvested maize by using bioactive antimicrobial compounds of L. coryniformis.
2. Results
2.1. Potential of Antimicrobial Compounds (AMCs)
The low molecular weight secondary antimicrobial compounds (AMCs) of L. coryniformis BCH-4 showed strong antimicrobial activity against tested pathogenic fungal and bacterial species. Clear zones of inhibition appeared (Figure 1) with mean inhibition (n = 3) of 15.00 ± 1.00, 14.66 ± 1.52, 9.00 ± 1.00 and 12.33 ± 0.57 mm, respectively, against pathogenic strains of Escherichia coli, Staphylococcus aureus, Aspergillus fumigatus, and Aspergillus flavus. No activity was observed in negative controls against these test strains.
Figure 1.
Antimicrobial activity of L. coryniformis BCH-4 ethyl acetate extracted antimicrobial compounds (AMCs) after 16 h of incubation for antibacterial and 48 h of incubation for antifungal activity. (A) E. coli (Gram-negative shiga toxin producing bacterial strain); (B) S. aureus (Gram-positive multi-drug resistant bacterial strain); (C) A. fumigatus (Saprotrophic filamentous fungus) (D) A. flavus (Aflatoxigenic filamentous fungus). de Man, Rogosa and Sharpe (MRS) broth was used as a negative control and the well diameter was 8 mm.
2.2. Antioxidant Activity (DPPH Scavenging Activity)
DPPH (2,2-Diphenyl-1-picrylhydrazyl) radical scavenging activity of AMCs produced by L. coryniformis BCH-4 showed potent activity in a concentration-dependent manner. Mean inhibition (± SD%) of DPPH activity at 25, 50 and 100 (μL/mL) was 30.28% ± 1.03%, 48.58% ± 0.50% and 61.66% ± 0.55%, respectively (n = 3). The results show that the highest concentration of AMCs tested contributes maximum scavenging of DPPH.
2.3. Comparative Antifungal Analysis of AMCs with Commercial Preservatives
A comparative antifungal study of extracted AMCs with FDA (Food and Drug Administration)-approved concentrations of preservatives (sodium benzoate and potassium sorbate) was carried out (Figure 2A,B). The AMC concentrations being studied showed maximum growth inhibition of A. fumigatus (8.98 ± 1.00 mm) and A. flavus (12.00 ± 0.56 mm) in comparison to the FDA-approved highest concentrations of sodium benzoate (0.2% w/v; 1.44 ± 0.57 mm) and potassium sorbate (0.1% w/v; ~0.00 mm) after 48 h of incubation.
Figure 2.
Inhibition zones of antifungal potential of L. coryniformis BCH-4 ethyl acetate extracted AMCs in comparison to commercial preservatives (sodium benzoate and potassium sorbate) against (A) A. fumigatus and (B) A. flavus at 30 °C after 48 h of incubation. Well diameter was 8 mm.
2.4. Efficiency of AMCs for Bioprotection of Maize
AMCs of L. coryniformis BCH-4 showed highly potent antimicrobial activity against pathogenic strains, therefore maize grains were used as a food model that is considered as a staple food in many countries and primarily affected by A. flavus during the storage period. In maize grains soaked with de Man, Rogosa and Sharpe (MRS) broth (control), dark green spores were observed after 48 h of incubation (Figure 3A). Meanwhile, few white mycelia of A. flavus were observed in 25% (v/v) and 50% (v/v) AMC concentration-treated maize, whereas no growth was observed in 75% (v/v) and 100% (v/v) treated concentrations (Figure 3B), even after 72 h.
Figure 3.
A. flavus growth on raw maize grains soaked with (A) MRS broth [25%, 50%, 75% and 100% (v/v)] as control and (B) L. coryniformis BCH-4 AMCs [25%, 50%, 75% and 100% (v/v) AMCs] treated maize grains after 48 and 72 h of incubation at 30 °C. Arrows indicate the white mycelia and/or green spores of A. flavus.
2.5. Proximate Analysis and β-Carotene Determination of Untreated and Treated Maize Grains
The proximate analysis of treatments A1 (raw maize grains), A2 (A. flavus inoculated maize grains) and A3 (A. flavus + AMCs inoculated maize grains) are summarized in Table 1. The moisture content of A2 was higher than A1 and A3, but there was no significant difference (p > 0.05) between the moisture contents of A1 and A3. Meanwhile, protein, fat, fiber and ash contents were significantly (p ≤ 0.05) decreased in A2 compared to in A1 and A3, as summarized in Table 1. Moreover, β-carotene contents in A1 and A3 were not statistically different, while a significant decrease has been observed in A2. Consequently, AMCs treatment produced by L. coryniformis BCH-4 significantly improved the nutritional values of maize grains and also protected them from A. flavus infestation.
Table 1.
Proximate analysis and β-carotene determination of un-treated and AMC-treated maize grains.
2.6. HPLC Analysis and Antifungal Potential of Low Molecular Weight Organic Acids
HPLC analysis of L. coryniformis BCH-4 AMCs revealed the presence of 2-oxopropanoic acid (Pyruvic acid), 2-hydroxypropane-1,2,3-tricarboxylic acid (Citric acid), 2-hydroxybutanedioic acid (Malic acid), 2-hydroxypropanoic acid (Lactic acid), propanedioic acid (Malonic acid) and butanedioic acid (Succinic acid) (Table 2; Figure 4).
Table 2.
Acid profile of L. coryniformis BCH-4 AMCs with their respective molecular weight, retention time and concentration.
Figure 4.
HPLC analysis of L. coryniformis BCH-4 AMCs for organic acids. The chromatogram has been labeled with peak retention time, i.e., 2-oxopropanoic acid (3.72 min), 2-hydroxypropane-1,2,3-tricarboxylic acid (5.05 min), 2-hydroxybutanedioic acid (6.41 min), 2-hydroxypropanoic acid (7.22 min), propanedioic acid (8.38 min) and butanedioic acid (15.94 min).
The observed concentrations (g/L) were individually tested for antifungal potential against A. flavus. Individual organic acids have the zone of inhibition as; 2-hydroxypropanoic acid (5.33 ± 1.15 mm), 2-hydroxypropane-1,2,3-tricarboxylic acid (6.66 ± 0.57 mm), propanedioic acid (5.00 ± 1.00 mm), 2-hydroxybutanedioic acid (3.00 ± 1.00 mm), 2-oxopropanoic acid (~0.00 ± 0.00 mm) and butanedioic acid (~0.00 ± 0.00 mm), while the synergic effect of these organic acids exhibited a 9.66 ± 0.57 mm zone of inhibition (Figure 5).
Figure 5.
Antifungal potential of HPLC identified organic acids in L. coryniformis BCH-4 AMCs against A. flavus. A = Combination of acids, B = 2-hydroxybutanedioic acid, C = propanedioic acid, D = 2-hydroxypropane-1,2,3-tricarboxylic acid, E = 2-oxopropanoic acid F = butanedioic acid and G = 2-hydroxypropanoic acid. Well diameter was 8 mm.
2.7. Fourier Transform Infrared (FTIR) Spectroscopy Analysis
The FTIR spectroscopic analysis of L. coryniformis BCH-4 AMCs revealed the presence of several functional groups (Figure 6). The intense peak at 3331 cm−1 represents the characteristic hydroxyl (OH) group. The peak at 2120 cm−1 shows the presence of the C-C triple bond (alkyne group), while the peak at 1638 cm−1 indicates the presence of C=O stretching. The absorption peak at 1377 cm−1 shows the presence of alkane groups, while that at 1270 cm−1 shows C-O (acid) stretching. The peaks at 1130 and 1045 cm−1 indicate the presence of esters and alkyl halides. In the FTIR analysis spectrum, the presence of OH, C=O, C-O and esters functional groups indicated the characteristics of different organic acids, phenolic acids and fatty acids, that were responsible for the L. coryniformis BCH-4 AMCs bioactivities.
Figure 6.
FTIR spectrum of L. coryniformis BCH-4 AMCs. The spectrum shows a range of 4000 to 500 cm−1 wave number (along x-axis) and % transmittance (along y-axis). The numbers above x-axis are representing specific functional group wave numbers (cm−1) which are present in L. coryniformis BCH-4 AMCs.
3. Discussion
Aspergillus niger, A. fumigatus, A. flavus, Fusarium oxysporum and Rhizopus stolonifer are the common pathogens of cereal grains in the field as well as during storage, that cause pre- and post-harvest spoilage in grains [11]. Chemical preservatives have been commonly used, although researches have shown concerns about their safety. Several studies have reported that these chemical preservatives may cause teratogenic, neurotoxic, and mutagenic effects [26]. Growth inhibition of pathogenic microorganisms by LAB and LAB AMCs looks to be a good biocontrol method [21] and suggests that they are good alternative to the chemical preservatives [27]. In the current study, in vitro bioactivities (antibacterial, antifungal and antioxidant) and the bioprotective potential of L. coryniformis BCH-4 AMCs to prevent the post-harvest loss in maize grains revealed promising results and it was observed that L. coryniformis BCH-4 AMCs had potent bioprotective potential against pathogens.
AMCs from L. coryniformis BCH-4 were extracted using ethyl acetate, a solvent that can extract a wide range of AMCs. The same solvent has been used for the extraction of AMCs produced by Bacillus cereus [28] and L. plantarum [29]. The findings of the current study show that L. coryniformis BCH-4 AMCs had potent in vitro antibacterial and antifungal activities (Figure 1) against tested pathogenic bacterial (E. coli and S. aureus) and fungal (A. fumigatus and A. flavus) strains. Inhibitory actions have also been reported for other Lactobacillus species, such as L. bulgaricus, L. casei, L. plantarum, L. fermentum against intestinal pathogens like E. coli, S. aureus, Shigella dysenteriae and Salmonella paratyphi A [30]. The AMCs of L. plantarum UM55 and L. buchneri UTAD104 also inhibited the growth of Penicillium nordicum, a foodborne pathogen [31]. Moreover, L. coryniformis BCH-4 AMCs also showed potent antioxidant activity (DPPH radical scavenging activity) in a concentration-dependent manner which is higher than reported earlier for other Lactobacillus species, such as L. curvatus SR6, which showed 59.67% ± 6.68% [32], while L. plantarum C88 exhibited 53.05% DPPH radical scavenging activity [33]. The DPPH scavenging activity assay was used because of its wide use, reliability, rapidness, simplicity and cost effectiveness as compared to other methods, e.g., ABTS. This assay is used to measure the ability of compounds to act as free radical scavengers or hydrogen donors, and to evaluate total antioxidant activity. It can also be used to quantify antioxidants in complex biological systems, for solid or liquid samples. It is a valid, accurate and highly reproducible method to evaluate radical scavenging activity of antioxidants, since the radical compound is stable and need not be generated. It also requires mild experimental conditions and is independent of sample polarity [34,35,36].
The wide spectrum of L. coryniformis BCH-4 AMCs has potential for several therapeutic applications. The remarkable antifungal activity of L. coryniformis AMCs against A. flavus (Figure 2A,B) make them a suitable and safe candidate for commercial applications [37] that can be used as good alternative to chemical preservatives [38,39]. The current study is the first report that describes the antifungal potential of L. coryniformis AMCs in comparison to FDA-approved food preservatives.
Moreover, L. coryniformis BCH-4 AMCs inhibited the growth of A. flavus on maize grains (Figure 3), while the proximate analysis (Table 1) showed that L. coryniformis BCH-4 AMCs significantly (p ≤ 0.05) improved the nutritional profile of treated maize grains. The increase in the nutritive value of maize is presumably due to addition of AMC extract that is a mixture of peptides, bacteriocins (protein in nature), exo-polysaccharides, fatty acids, organic acids, etc. [40,41]. The increase in moisture content of A. flavus-inoculated maize grains (A2) could be attributed to the hydrolysis of cellulose and pectin components of the cell wall by A. flavus as a possible mechanism of invasion and subsequent infection of maize tissue [42]. The crude fiber, fat, ash, protein and β-carotene contents were also significantly (p ≤ 0.05) decreased in A2 because protein, fiber and fat contents might have been broken down by pathogenic fungi into smaller molecules that are metabolized. Meanwhile, the ash content can be decreased in infected food due to the secretion of cell wall-degrading enzymes and by the toxin production of pathogens [43], while β-carotene can be broken down into β-ionone [44]. Complex molecules such as protein and polysaccharide are required by fungi to build up the hyphal wall and for obtaining energy by respiration [11,45]. Earlier reports describing the biopreservative property of L. plantarum AMCs against A. flavus used soybeans as a food model [39]. Khanafari et al. [46] also reported the bioprotective effects of L. plantarum PTCC 1058 against A. flavus in maize seeds. In that study, HPLC analysis clearly showed that A. flavus growth was 100% inhibited in L. plantarum inoculated maize seeds. In another study, 37 peptides identified in L. plantarum TE10 reduced the A. flavus growth on selected (GWG 111) maize seeds [47]. However, no study has been found that described the nutritional contents of cereals grains after the application of LAB compounds and/or the pathogenic effects of A. flavus on nutritional components. Meanwhile, the results of the current study clearly demonstrate that pathogens utilized the essential nutrients after infestation through their degradation activities [11,45].
HPLC analysis of L. coryniformis BCH-4 AMCs showed the presence of 2-oxopropanoic acid, 2-hydroxypropane-1,2,3-tricarboxylic acid, 2-hydroxybutanedioic acid, 2-hydroxypropanoic acid, propanedioic acid and butanedioic acid (Table 2). The individual and synergistic antifungal effect against A. flavus (Figure 5) showed the antimicrobial potential of organic acids. Organic acids such as lactic acid (2-hydroxypropanoic acid), citric acid (2-hydroxypropane-1,2,3-tricarboxylic acid), malic acid (2-hydroxybutanedioic acid), succinic acid (butanedioic acid) and malonic acid (propanedioic acid) are used as pH regulators, flavor enhancers, baking additives and biopreservatives in the food industry [48,49]. However, these results (synergic effect 9.66 ± 0.57 mm zone of inhibition) indicated that antifungal activity of L. coryniformis BCH-4 AMCs against A. flavus (12.33 ± 0.57 mm zone of inhibition) can also be contributed by other AMCs in addition to organic acids.
Moreover, the FTIR spectroscopic analysis (Figure 6) further validated the HPLC and antifungal results of L. coryniformis BCH-4 AMCs. The presence of hydroxyl (OH) 3331 cm−1 (3570–3200 cm−1) [50,51], alkyne 2120 cm−1 (2260–2100 cm−1), carbonyl 1638 cm−1 (1650–1600 cm−1) [51], alkane 1377 cm−1 (1480–1345 cm−1) [52], C-O 1270 cm−1 (1320–1210 cm−1) [51] and esters and alkyl halides groups 1130 and 1045 cm−1, respectively (1400–1000 cm−1) [52], demonstrated the characteristics of different organic acids [53] as well as other AMCs present in L. coryniformis BCH-4. The hydroxyl (OH) group’s presence in FTIR can be attributed to phenolic compounds which have already been reported in Lactobacillus species [54]. Different fatty acids are also present in LAB such as hydroxyisocapric acid, decanoic acid and 3-hydroxydecanoic acid isolated from L. reuteri ee1p that have great potential against dermatophytes [55]. Similarly, the hexadecenoic acid, 9,12-otadecadienoic acid (Z,Z)-methyl ester and methyl ester fatty acids have been found in L. plantarum and L. coryniformis [18]. The literature about L. coryniformis species is barely available, while the findings of the current study demonstrate the potential applications of L. coryniformis AMCs as safe natural alternatives to chemical preservatives for bioprotection of cereal grains against pathogen spoilage and to increase their nutritional values.
4. Materials and Methods
4.1. Chemicals, Reagents and Maize Grains
The de Man, Rogosa and Sharpe (MRS) agar/broth, glycerol (Analytical grade), nutrient agar/broth, Vogel’s agar/broth, ethyl acetate (HPLC grade), 2,2-diphenyl-1-picrylhydrazyl (DPPH), 2-oxopropanoic acid (pyruvic acid), 2-hydroxypropane-1,2,3-tricarboxylic acid (citric acid), 2-hydroxybutanedioic acid (malic acid), 2-hydroxypropanoic acid (malonic acid), propanedioic acid (lactic acid), butanedioic acid (succinic acid), β-carotene, sodium benzoate, potassium sorbate and sodium acetate were mainly purchased from Sigma-Aldrich, St. Louis, MO, USA. Maize grains (FMC Variety C-7065) were collected from a grain market in Faisalabad, Pakistan.
4.2. Microbial Cultures and Growth Media
Lactobacillus coryniformis BCH-4 (KX388387), previously isolated from fermented rice rinsed water with lactose as a carbon source [18] was cultured aerobically on MRS agar/broth at 37 °C for 48 h and preserved at −80 °C for long term storage in 15% (v/v) glycerol. Laboratory standard pathogenic strains were also available in the Industrial Biotechnology Lab, Department of Bioinformatics and Biotechnology, GCUF, Faisalabad, Pakistan. Tested bacterial strains Escherichia coli and Staphylococcus aureus were grown on nutrient medium at 37 °C for 16 h, while fungal strains Aspergillus flavus and Aspergillus fumigatus were grown on Vogel’s medium at 30 °C for 48 h before storage at 4 °C.
4.3. Extraction of Antimicrobial Compounds (AMCs)
L. coryniformis BCH-4 was cultured in 6L of MRS broth (pH 6.4 ± 0.2) at 37 °C for 72 h with constant stirring at 120 rpm in the fermenter (BioFer-010, ICCC, Islamabad, Pakistan). After 72 h, cell-free supernatant (CFS) of L. coryniforims BCH-4 was prepared by centrifugation (Z326K, Hermle, Wehingen, Germany) at 6000 rpm (4430× g) for 10 min at 4 °C and subsequently filtered through sterilized 0.22 μm pore-size filters (Advantec Toyo Kaisha, Ltd. Tokyo, Japan). AMCs were extracted from filter-sterilized CFS by the solvent phase extraction according to Wang et al. [56], with a few modifications. Ethyl acetate was used as an extracting solvent and AMCs were extracted by mixing same ratio of CFS and solvent [150 mL:150 mL] in an Erlenmeyer flask followed by shaking at 120 rpm on table-top shaker (Phoenix RS-OS 10, Irmeco, Lütjensee, Germany) for 2 h at room temperature. Mixture was poured in a separating funnel and allowed to stand until organic and aqueous phases were separated. The organic phase was collected, and the aqueous phase was further used to extract the maximum amount of AMCs in CFS. This process was repeated three times and organic phase was combined, concentrated by rotary evaporator (Rotavapor® R-2100, Buchi, Flawil, Switzerland) under vacuum at lower than 40 °C. Ethyl acetate was evaporated and extracted dark brown concentrated (viscous) compounds were further evaluated for their bioactive potential.
4.4. Antimicrobial Activity
Antimicrobial activity assay was carried out by the agar well diffusion method [57] under aerobic conditions. Agar medium was prepared and poured into Petri dishes. Pathogenic bacterial strains (108 CFU/mL) and fungal strains (106 Spores/mL) as mentioned earlier were spread using sterile cotton swab over the plates and 8 mm diameter wells were punched into agar medium using a sterile cork borer. Then, 60 μL of extracted compounds was loaded into each well after diluting with distilled water (Water:AMCs 1:3). Non-inoculated MRS broth was used as a negative control. The plates were incubated for 16 h at 37 °C for antibacterial and for 48 h at 30 °C for antifungal activity. The antimicrobial potential was measured in millimeters (mm) as inhibition zones around wells using a ruler. The assay was performed in triplicate. Antimicrobial activity was determined by following the formula below [58]:
Diameter of zone of growth inhibition around the well (mm) − diameter of well (8 mm)
4.5. Antioxidant Activity
2,2-diphenyl-1-picrylhydrazyl (DPPH) scavenging activity was performed to evaluate the antioxidant potential of extracted compounds according to the method of Gangwar et al. [59], with a few modifications. One milliliter of 25, 50, 100 (μL/mL) concentrations of AMCs was mixed with 1 mL of DPPH ethanol (0.2 mM) solution and the reaction was left to stand at room temperature for 30 min. The absorbance of the sample (A1) was determined at 517 nm, while ethanolic DPPH solution (A0) was used as a control. The assay was performed in triplicate. The inhibition percentage (%) was calculated by the following equation:
where A0 is the absorbance of the DPPH solution and A1 is the absorbance of the sample.
DPPH radical scavenging age% = [(A0 − A1)/A0] × 100
4.6. Comparison of Antifungal Activity of AMCs with Commercial Preservatives
The antifungal potential of AMCs was compared with commercially available and FDA-approved preservatives. Sodium benzoate and potassium sorbate (dissolved in 20 mM sodium acetate buffer, pH 4) were used at the concentrations of 0.05%, 0.1%, 0.2% (w/v) and 0.01%, 0.05%, 0.1% (w/v), respectively (FDA-approved values). The antifungal activity was determined as described previously in the agar well diffusion method [57,58] at 30 °C after 48 h of incubation.
4.7. Bioprotection of Maize Using AMCs
The antimicrobial compounds (AMCs) produced by L. coryniformis BCH-4 were used for the bioprotection of maize according to the method developed by Yang and Chang [39], with minor modifications. After washing with distilled water, maize grains were soaked in extracted AMCs with different concentrations, prepared in sterilized distilled water [25%, 50%, 75%, and 100% (v/v) AMCs] for 8 h at room temperature. Six maize grains of each concentration were shifted to sterilized Petri plates. Besides this, maize grains soaked in MRS broth of different concentrations [25%, 50%, 75%, and 100% (v/v)] were used as a control. A. flavus spore suspension (106 Spores/mL) was prepared and 12 μL of the suspension was spread on each maize grain in Petri plates. Inoculated maize grains were incubated at 30 °C and were examined after 48 and 72 h. The reason for selecting only A. flavus in this experiment is that it predominantly affects the maize grains [47].
4.8. Proximate Analysis
The proximate analysis was carried out at the Post Harvest Research Centre (Ayub Agricultural Research Institute, Faisalabad, Pakistan). The quality of untreated (raw) and treated maize grains was examined by calculating moisture, protein, fat, fiber and ash contents. Samples and solutions were prepared according to the methods of the Association of Officiating Analytical Chemists [60]. The untreated sample (raw maize grains) was labeled as A1, while the treated samples—A. flavus inoculated maize grains and A. flavus + AMCs inoculated maize grains—were labeled as A2 and A3, respectively.
4.9. Estimation of β-Carotene in Raw and Treated Maize
The concentration of β-carotene was determined according to Junpatiw et al. [61], with minor modifications. Freshly weighed 0.5 g of raw and treated maize grains were ground separately and mixed with 6 mL absolute ethanol containing 0.1% (w/v) butylated hydroxytoluene using a vortex mixer. The sample mixtures were placed in a water bath for 5 min at 85 °C. After that, 120 µL of (80% w/v) potassium hydroxide was added, vortexed and put in a water bath for 10 min at 85 °C to hydrolyze the carotenol ester present in sample mixtures. During saponification process, the samples were vortexed after every 5 min. In the samples, 3 mL of cold deionized water was added and then placed immediately in the ice bath. Furthermore, the samples were centrifuged at 3500 rpm (1400× g) for 5 min after adding and mixing 3 mL of petroleum ether and diethyl ether (2:1, v/v). The organic supernatant phase was collected after centrifugation and analyzed on HPLC (LC-10A, Shimadzu, Kyoto, Japan) equipped with YMC C30 5 μm, 4.6 × 250 mm carotenoid column (Waters, Milford, MA, USA). An isocratic mobile phase system consisting of acetonitrile:dichloromethane:methanol (70:20:10, v/v) was used with a flow rate of 1.0 mL/min and monitored at 450 nm with the help of UV-Vis detector (SPD-10A VP, Shimadzu, Kyoto, Japan). The carotenoid concentration in raw and treated maize grains was expressed as µg/100 g.
4.10. Determination of Organic Acids in AMCs Using High Performance Liquid Chromatography (HPLC)
For the analysis of organic acids, AMCs were mixed well by vortex, filtered through 0.22 μm syringe filter (Advantec Toyo Kaisha, Ltd. Tokyo, Japan) and injected in HPLC system (LC-10A, Shimadzu, Kyoto, Japan) fitted with Shim-Pack CLC-ODS (C-18), 5 μm, 25 cm × 4.6 mm column, Shimadzu LC-10AT pump and UV-Vis detector (SPD-10A VP, Shimadzu, Kyoto, Japan). The isocratic mobile phase (0.1% v/v H3PO4) with 0.5 mL/min flow rate at room temperature was used. The elute was observed at 215 nm by UV-Vis detector, data were collected and processed using the 32KARAT software operating system by default method for channel 2 of 2-oxopropanoic acid, 2-hydroxypropane-1,2,3-tricarboxylic acid, 2-hydroxybutanedioic acid, 2-hydroxypropanoic acid, propanedioic acid and butanedioic acid [18].
4.11. Antifungal Activity of Organic Acids
The determined concentrations of organic acids by HPLC were evaluated separately for antifungal potential against Aspergillus flavus. The antifungal activity of individual organic acids and their synergistic effect were determined using the plate method at 30 °C for 48 h as described previously [57,58].
4.12. Determination of Functional Groups by Fourier Transform Infrared (FTIR) Spectroscopy
FTIR spectroscopic analysis was done for the identification of specific functional groups [51]. The infrared absorption spectrum was recorded on the FTIR spectrophotometer (Tensor II, Bruker, Billerica, MA, USA) in the 4000 to 500 cm−1 region and spectrum was obtained as wave number versus percentage (%) transmittance.
4.13. Statistical Analysis
The zones of inhibition and antioxidant activity were calculated as the mean ± standard deviation of three replicates (n = 3). Meanwhile, one-way ANOVA (mean ± standard error) was performed for proximate analysis treatments (n = 3) using SPSS software package (Version 23.0, IBM Corporation, Armonk, NY, USA). Moreover, treatment means were separated by using Tukey’s HSD (Honest Significant Difference) at a significance level of 0.05. Differences at p ≤ 0.05 were considered significant.
5. Conclusions
The work represents a comprehensive analysis of the L. coryniformis BCH-4 antimicrobial compounds (AMCs) as antimicrobial, antioxidant and bioprotective agents of cereal grains. L. coryniformis AMCs were found to have strong inhibitory activity against food pathogens. The results highlight the higher nutritional value of AMC-treated maize grains than raw or A. flavus-infected maize grains. The detailed characterization of LAB (as starters, biocontrol agents, nutraceuticals and probiotics) can provide solid evidence-based support for their beneficial effects. It is also a promising approach to obtain functional foods and enhanced shelf life. In future, this work can be further extended to purify L. coryniformis AMCs for their potential use in the food industry and agriculture sectors.
Author Contributions
Conceptualization, M.S. and M.R.J.; Methodology, M.S., A.T., S.N. and M.R.J.; Software, A.I.; Validation, A.T. and M.R.J.; Formal analysis, A.T., A.H., E.F.A. and M.H.S.; Investigation, A.T. and A.I.; Resources, M.R.J.; Data curation, A.T. and S.N.; Writing—original draft preparation, A.T., A.I., A.H. and E.F.A.; Writing—review and editing, M.S., S.N., M.H.S. and M.R.J.; Visualization, M.R.J.; Supervision, M.S. and M.R.J.; Project administration, M.R.J.; Funding acquisition, A.H., E.F.A. and M.H.S. All authors have read and agreed to the published version of the manuscript.
Funding
This research received external funding from Researchers Supporting Project Number (RSP-2020/134), King Saud University, Riyadh, Saudi Arabia.
Acknowledgments
The facilities and support provided by the Department of Bioinformatics and Biotechnology; Government College University Faisalabad (GCUF) are highly acknowledged. The authors would like to extend their sincere appreciation to the Researchers Supporting Project Number (RSP-2020/134), King Saud University, Riyadh, Saudi Arabia.
Conflicts of Interest
The authors declare no conflict of interest.
Abbreviations
| LAB | Lactic acid bacteria |
| CFS | Cell free supernatant |
| AMCs | Antimicrobial compounds |
| DPPH | 2,2-Diphenyl-1-picrylhydrazyl |
| HPLC | High performance liquid chromatography |
| FTIR | Fourier transform infrared spectroscopy |
References
- Rather, I.A.; Seo, B.; Kumar, V.R.; Choi, U.-H.; Choi, K.-H.; Lim, J.; Park, Y.-H. Isolation and characterization of a proteinaceous antifungal compound from Lactobacillus plantarum YML007 and its application as a food preservative. Lett. Appl. Microbiol. 2013, 57, 69–76. [Google Scholar] [CrossRef] [PubMed]
- Oliveira, P.M.; Zannini, E.; Arendt, E.K. Cereal fungal infection, mycotoxins, and lactic acid bacteria mediated bioprotection: From crop farming to cereal products. Food Microbiol. 2014, 37, 78–95. [Google Scholar] [CrossRef] [PubMed]
- Choquer, M.; Fournier, E.; Kunz, C.; Levis, C.; Pradier, J.-M.; Simon, A.; Viaud, M. Botrytis cinereavirulence factors: New insights into a necrotrophic and polyphageous pathogen. FEMS Microbiol. Lett. 2007, 277, 1–10. [Google Scholar] [CrossRef] [PubMed]
- Gonçalves, A.; Gkrillas, A.; Dorne, J.L.; Dall’Asta, C.; Palumbo, R.; Lima, N.; Battilani, P.; Venâncio, A.; Giorni, P. Pre- and Postharvest Strategies to Minimize Mycotoxin Contamination in the Rice Food Chain. Compr. Rev. Food Sci. Food Saf. 2019, 18, 441–454. [Google Scholar] [CrossRef]
- Zalewski, K.; Lahuta, L.B.; Martysiak-Żurowska, D.; Okorski, A.; Nitkiewicz, B.; Zielonka, Ł. Effect of Exogenous Application of Methyl Jasmonate on the Lipid and Carbohydrate Content and Composition of Winter Triticale (Triticosecale Wittm.) Grain and the Severity of Fungal Infections in Triticale Plants and Grain. J. Agric. Food Chem. 2019, 67, 5932–5939. [Google Scholar] [CrossRef] [PubMed]
- Schmidt, M.; Zannini, E.; Lynch, K.M.; Arendt, E. Novel approaches for chemical and microbiological shelf life extension of cereal crops. Crit. Rev. Food Sci. Nutr. 2018, 59, 3395–3419. [Google Scholar] [CrossRef] [PubMed]
- Befikadu, D. Factors affecting quality of grain stored in Ethiopian traditional storage structures and opportunities for improvement. Int. J. Sci. Basic Appl. Res. 2014, 18, 235–257. [Google Scholar]
- Shiju, M. A review on the effect of fungi on the wheat grain under post harvest storage ecology. Food Environ. Safety J. 2010, 9, 87–96. [Google Scholar]
- Abdullah, N.; Nawawi, A.; Othman, I. Fungal spoilage of starch-based foods in relation to its water activity (aw). J. Stored Prod. Res. 2000, 36, 47–54. [Google Scholar] [CrossRef]
- Shiferaw, B.; Prasanna, B.M.; Hellin, J.; Bänziger, M. Crops that feed the world 6. Past successes and future challenges to the role played by maize in global food security. Food Secur. 2011, 3, 307–327. [Google Scholar] [CrossRef]
- Akwaji, P.; Umana, E.; Okon, E. Phytochemical and antifungal activity of leaf extracts of Corchorus olitorius and Gongronema latifolium on fungi associated with post-harvest deterioration of maize (Zea mays) seeds in Oban community, Nigeria. World Sci. News 2016, 53, 157–177. [Google Scholar]
- Suleiman, R.; Rosentrater, K.; Bern, C. Effects of deterioration parameters on storage of maize: A review. J. Nat. Sci. Res. 2013, 3, 147–165. [Google Scholar]
- Anand, S.; Sati, N. Artificial preservatives and their harmful effects: Looking toward nature for safer alternatives. Int. J. Pharm. Sci. Res. 2013, 4, 2496. [Google Scholar] [CrossRef]
- Moschetto, F.A.; Lopes, M.F.; Silva, B.P.; Neto, M.C.L. Sodium benzoate inhibits germination, establishment and development of rice plants. Theor. Exp. Plant Physiol. 2019, 31, 377–385. [Google Scholar] [CrossRef]
- Gregirchak, N.; Stabnikova, O.; Stabnikov, V. Application of Lactic Acid Bacteria for Coating of Wheat Bread to Protect it from Microbial Spoilage. Plant Foods Hum. Nutr. 2020, 75, 223–229. [Google Scholar] [CrossRef]
- Kitagawa, N.; Otani, T.; Inai, T. Nisin, a food preservative produced by Lactococcus lactis, affects the localization pattern of intermediate filament protein in HaCaT cells. Anat. Sci. Int. 2018, 94, 163–171. [Google Scholar] [CrossRef]
- Schnürer, J.; Magnusson, J. Antifungal lactic acid bacteria as biopreservatives. Trends Food Sci. Technol. 2005, 16, 70–78. [Google Scholar] [CrossRef]
- Bukhari, S.A.; Salman, M.; Numan, M.; Javed, M.R.; Zubair, M.; Mustafa, G. Characterization of antifungal metabolites produced by Lactobacillus plantarum and Lactobacillus coryniformis isolated from rice rinsed water. Mol. Biol. Rep. 2020, 47, 1871–1881. [Google Scholar] [CrossRef]
- Hatti-Kaul, R.; Chen, L.; Dishisha, T.; El Enshasy, H.A. Lactic acid bacteria: From starter cultures to producers of chemicals. FEMS Microbiol. Lett. 2018, 365. [Google Scholar] [CrossRef]
- Azat, R.; Liu, Y.; Li, W.; Kayir, A.; Lin, D.-B.; Zhou, W.-W.; Zheng, X. Probiotic properties of lactic acid bacteria isolated from traditionally fermented Xinjiang cheese. J. Zhejiang Univ. Sci. B 2016, 17, 597–609. [Google Scholar] [CrossRef]
- Crowley, S.; Mahony, J.; Van Sinderen, D. Current perspectives on antifungal lactic acid bacteria as natural bio-preservatives. Trends Food Sci. Technol. 2013, 33, 93–109. [Google Scholar] [CrossRef]
- Siedler, S.; Balti, R.; Neves, A.R. Bioprotective mechanisms of lactic acid bacteria against fungal spoilage of food. Curr. Opin. Biotechnol. 2019, 56, 138–146. [Google Scholar] [CrossRef] [PubMed]
- Ozogul, F.; Hamed, I. The importance of lactic acid bacteria for the prevention of bacterial growth and their biogenic amines formation: A review. Crit. Rev. Food Sci. Nutr. 2017, 58, 1660–1670. [Google Scholar] [CrossRef] [PubMed]
- Martin, R.; Olivares, M.; Marin, M.; Xaus, J.; Fernández, L.; Rodríguez, J.M. Characterization of a reuterin-producing Lactobacillus coryniformis strain isolated from a goat’s milk cheese. Int. J. Food Microbiol. 2005, 104, 267–277. [Google Scholar] [CrossRef] [PubMed]
- Magnusson, J.; Schnürer, J. Lactobacillus coryniformis subsp. coryniformis Strain Si3 Produces a Broad-Spectrum Proteinaceous Antifungal Compound. Appl. Environ. Microbiol. 2001, 67, 1–5. [Google Scholar] [CrossRef] [PubMed]
- Piper, J.D.; Piper, P.W. Benzoate and Sorbate Salts: A Systematic Review of the Potential Hazards of These Invaluable Preservatives and the Expanding Spectrum of Clinical Uses for Sodium Benzoate. Compr. Rev. Food Sci. Food Saf. 2017, 16, 868–880. [Google Scholar] [CrossRef]
- Singh, V.P. Recent approaches in food bio-preservation—A review. Open Veter. J. 2018, 8, 104–111. [Google Scholar] [CrossRef]
- Kumar, S.N.; Mohandas, C.; Nambisan, B. Purification of an antifungal compound, cyclo(l-Pro-d-Leu) for cereals produced by Bacillus cereus subsp. thuringiensis associated with entomopathogenic nematode. Microbiol. Res. 2013, 168, 278–288. [Google Scholar] [CrossRef]
- Lavermicocca, P.; Valerio, F.; Evidente, A.; Lazzaroni, S.; Corsetti, A.; Gobbetti, M. Purification and Characterization of Novel Antifungal Compounds from the Sourdough Lactobacillus plantarum Strain 21B. Appl. Environ. Microbiol. 2000, 66, 4084–4090. [Google Scholar] [CrossRef]
- Tebyanian, H.; Bakhtiari, A.; Karami, A.; Kariminik, A. Antimicrobial Activity of some Lactobacillus Species against Intestinal Pathogenic Bacteria. Int. Lett. Nat. Sci. 2017, 65, 10–15. [Google Scholar] [CrossRef]
- Guimarães, A.; Venâncio, A.; Abrunhosa, L. Antifungal effect of organic acids from lactic acid bacteria on Penicillium nordicum. Food Addit. Contam. 2018, 35, 1803–1818. [Google Scholar] [CrossRef] [PubMed]
- Zhang, Y.; Hu, P.; Lou, L.; Zhan, J.; Fan, M.; Li, D.; Liao, Q. Antioxidant Activities of Lactic Acid Bacteria for Quality Improvement of Fermented Sausage. J. Food Sci. 2017, 82, 2960–2967. [Google Scholar] [CrossRef] [PubMed]
- Li, S.; Zhao, Y.; Zhang, L.; Zhang, X.; Huang, L.; Li, D.; Niu, C.; Yang, Z.; Wang, Q. Antioxidant activity of Lactobacillus plantarum strains isolated from traditional Chinese fermented foods. Food Chem. 2012, 135, 1914–1919. [Google Scholar] [CrossRef] [PubMed]
- Koleva, I.I.; Van Beek, T.A.; Linssen, J.P.H.; De Groot, A.; Evstatieva, L.N. Screening of Plant Extracts for Antioxidant Activity: A Comparative Study on Three Testing Methods. Phytochem. Anal. 2002, 13, 8–17. [Google Scholar] [CrossRef]
- Kedare, S.B.; Singh, R.P. Genesis and development of DPPH method of antioxidant assay. J. Food Sci. Technol. 2011, 48, 412–422. [Google Scholar] [CrossRef]
- Shah, P.; Modi, H.A. Comparative study of DPPH, ABTS and FRAP assays for determination of antioxidant activity. Int. J. Res. Appl. Sci. Eng. Technol. 2015, 3, 636–641. [Google Scholar]
- Lara-Villoslada, F.; Sierra, S.; Martin, R.; Delgado, S.; Rodríguez, J.M.; Olivares, M.; Xaus, J. Safety assessment of two probiotic strains, Lactobacillus coryniformis CECT5711 and Lactobacillus gasseri CECT5714. J. Appl. Microbiol. 2007, 103, 175–184. [Google Scholar] [CrossRef]
- Ryu, E.H.; Yang, E.J.; Woo, E.R.; Chang, H.C. Purification and characterization of antifungal compounds from Lactobacillus plantarum HD1 isolated from kimchi. Food Microbiol. 2014, 41, 19–26. [Google Scholar] [CrossRef]
- Yang, E.; Chang, H.C. Purification of a new antifungal compound produced by Lactobacillus plantarum AF1 isolated from kimchi. Int. J. Food Microbiol. 2010, 139, 56–63. [Google Scholar] [CrossRef]
- Pessione, E.; Cirrincione, S. Bioactive Molecules Released in Food by Lactic Acid Bacteria: Encrypted Peptides and Biogenic Amines. Front. Microbiol. 2016, 7, 876. [Google Scholar] [CrossRef]
- Swain, M.R.; Ray, R.C. Nutritional values and bioactive compounds in lactic acid fermented vegetables and fruits. In Lactic Acid Fermentation of Fruits and Vegetables; Paramithiotis, S., Ed.; CRC Press: Boca Raton, FL, USA, 2017; Volume 1, pp. 37–52. [Google Scholar]
- Shehu, K.; Aliero, A. Effects of purple blotch infection on the proximate and mineral contents of onion leaf. Int. J. Pharma Sci. Res. 2010, 1, 131–133. [Google Scholar]
- Sawant, S.G.; Gawai, D.U. Effect of fungal infections on nutritional value of papaya fruits. Curr. Bot. 2011, 2, 43–44. [Google Scholar]
- Norton, R.A. Effect of Carotenoids on Aflatoxin B1 Synthesis by Aspergillus flavus. Phytopathology 1997, 87, 814–821. [Google Scholar] [CrossRef] [PubMed]
- Umana, E.J.; Ishoro, A.P.; Okey, E.N.; Akpan, J.B. Mycoflora associated with cocoa (Theobroma cacao) pods obtained in the field and their effects on seed nutritional contents. J. Agric. Crop Res. 2014, 2, 236–241. [Google Scholar]
- Khanafari, A.; Soudi, H.; Miraboulfathi, M. Biocontrol of Aspergillus flavus and aflatoxin B1 production in corn. J. Environ. Health Sci. Eng. 2007, 4, 163–168. [Google Scholar]
- Muhialdin, B.J.; Algboory, H.L.; Kadum, H.; Mohammed, N.K.; Saari, N.; Hassan, Z.; Hussin, A.S.M. Antifungal activity determination for the peptides generated by Lactobacillus plantarum TE10 against Aspergillus flavus in maize seeds. Food Control. 2020, 109, 106898. [Google Scholar] [CrossRef]
- Anyasi, T.A.; Jideani, A.I.O.; Mchau, G.R. Effect of organic acid pretreatment on some physical, functional and antioxidant properties of flour obtained from three unripe banana cultivars. Food Chem. 2015, 172, 515–522. [Google Scholar] [CrossRef]
- Quitmann, H.; Fan, R.; Czermak, P. Acidic organic compounds in beverage, food, and feed production. In Biotechnology of Food and Feed Additives; Zorn, H., Czermak, P., Eds.; Springer: Berlin/Heidelberg, Germany, 2013; Volume 143, pp. 91–141. [Google Scholar]
- Ashokkumar, R.; Ramaswamy, M. Phytochemical screening by FTIR spectroscopic analysis of leaf extracts of selected Indian medicinal plants. Int. J. Curr. Microbiol. Appl. Sci. 2014, 3, 395–406. [Google Scholar]
- Hemmalakshmi, S.; Priyanga, S.; Devaki, K. Fourier Transform Infra-Red spectroscopy analysis of Erythrina variegata L. J. Pharm. Sci. Res. 2017, 9, 2062–2067. [Google Scholar]
- Hari, N.; Nair, V.P. FTIR spectroscopic analysis of leaf extract in hexane in Jasminum azoricum L. IJSRST 2018, 4, 170–172. [Google Scholar]
- Moreira, J.L.; Santos, L. Analysis of organic acids in wines by Fourier-transform infrared spectroscopy. Anal. Bioanal. Chem. 2005, 382, 421–425. [Google Scholar] [CrossRef] [PubMed]
- Couto, J.A.; Campos, F.M.; Figueiredo, A.R.; Hogg, T.A. Ability of lactic acid bacteria to produce volatile phenols. Am. J. Enol. Vitic. 2006, 57, 166–171. [Google Scholar]
- Guo, J.; Brosnan, B.; Furey, A.; Arendt, E.; Murphy, P.; Coffey, A. Antifungal activity of Lactobacillus against Microsporum canis, Microsporum gypseum and Epidermophyton floccosum. Bioengineered 2012, 3, 104–113. [Google Scholar] [CrossRef] [PubMed]
- Wang, H.; Yan, Y.; Wang, J.; Zhang, H.; Qi, W. Production and Characterization of Antifungal Compounds Produced by Lactobacillus plantarum IMAU10014. PLoS ONE 2012, 7, e29452. [Google Scholar] [CrossRef]
- Cizeikiene, D.; Juodeikiene, G.; Paškevičius, A.; Bartkiene, E. Antimicrobial activity of lactic acid bacteria against pathogenic and spoilage microorganism isolated from food and their control in wheat bread. Food Control. 2013, 31, 539–545. [Google Scholar] [CrossRef]
- Zola, F.G.; Rodrigues, A.C.; Oliveira, B.D.; Sacramento, N.T.B.; Taylor, J.G.; Pinto, U.M.; Bertoldi, M.C. Mineral and centesimal contents, antioxidant activity and antimicrobial action of phenolic compounds from Eugenia Brasiliensis Lam. Pulp. Food Sci. Technol. 2019, 39, 378–385. [Google Scholar] [CrossRef]
- Gangwar, M.; Gautam, M.K.; Sharma, A.K.; Tripathi, Y.B.; Goel, R.K.; Nath, G. Antioxidant Capacity and Radical Scavenging Effect of Polyphenol Rich Mallotus philippenensis Fruit Extract on Human Erythrocytes: An In Vitro Study. Sci. World J. 2014, 2014, 1–12. [Google Scholar] [CrossRef]
- Association of Officiating Analytical Chemists. Official Method of Analysis, 18th ed.; Association of Officiating Analytical Chemists: Washington, DC, USA, 2005. [Google Scholar]
- Junpatiw, A.; Lertrat, K.; Lomthaisong, K.; Tangwongchai, R. Effects of steaming, boiling and frozen storage on carotenoid contents of various sweet corn cultivars. Int. Food. Res. J. 2013, 20, 2219. [Google Scholar]
Sample Availability: Samples of the Lactobacillus coryniformis BCH-4 AMCs are available from the authors. Publisher’s Note: MDPI stays neutral with regard to jurisdictional claims in published maps and institutional affiliations. |
© 2020 by the authors. Licensee MDPI, Basel, Switzerland. This article is an open access article distributed under the terms and conditions of the Creative Commons Attribution (CC BY) license (http://creativecommons.org/licenses/by/4.0/).